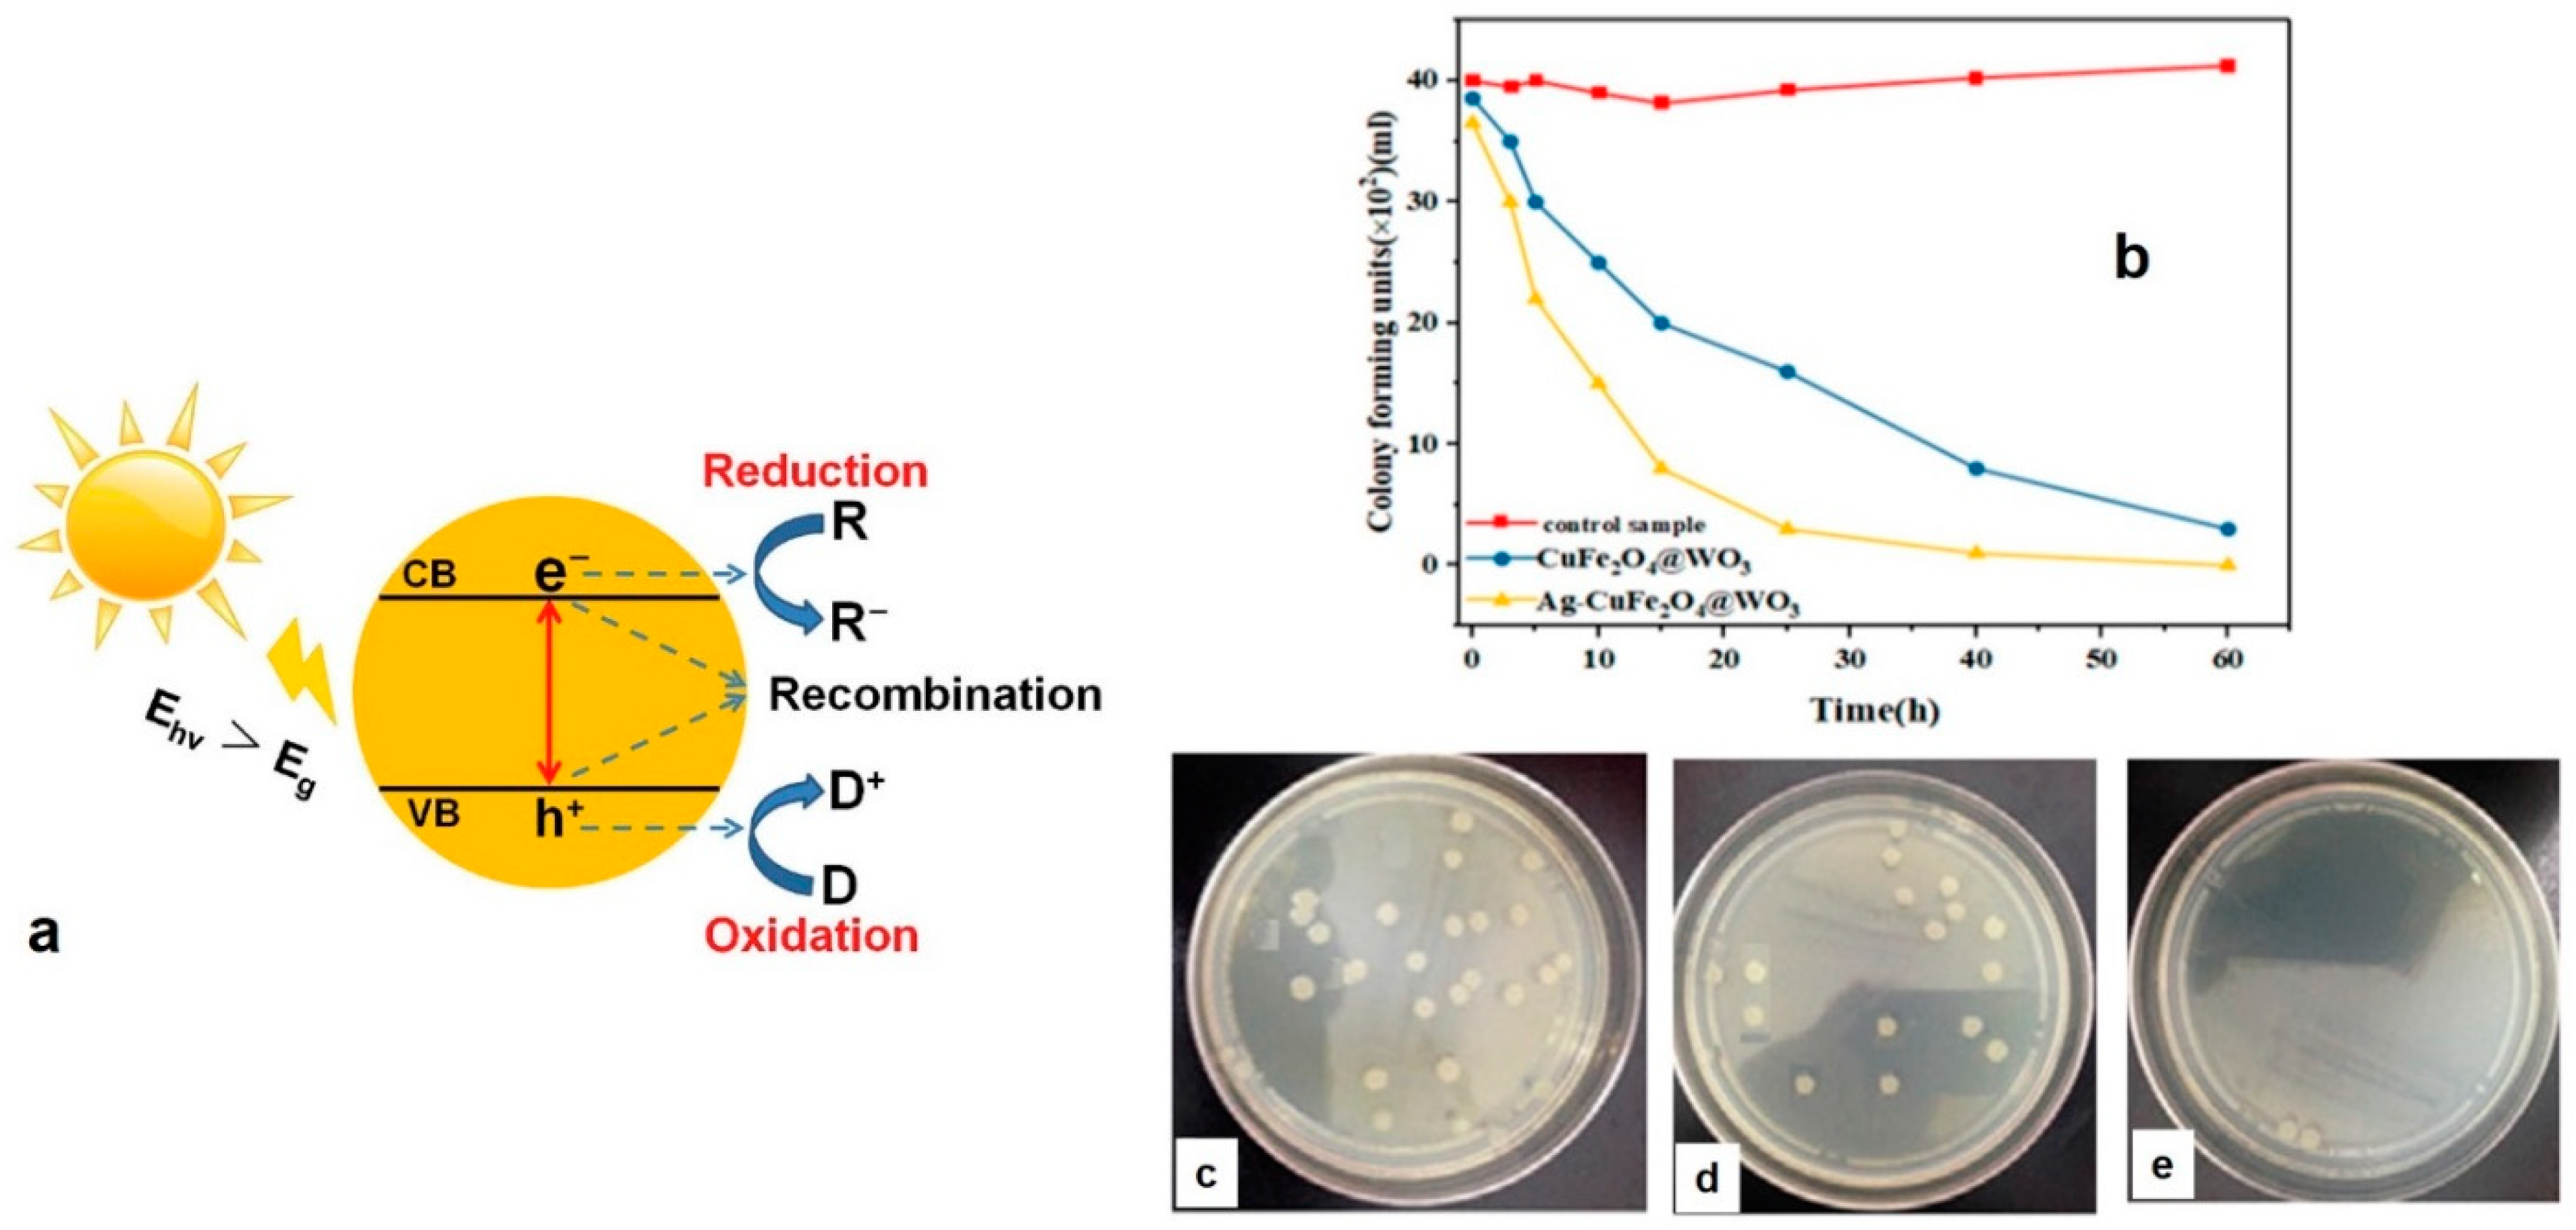
Polymers 13 02833 g005

Abstract
The COVID-19 pandemic has driven a global research to uncover novel, effective therapeutical and diagnosis approaches. In addition, control of spread of infection has been targeted through development of preventive tools and measures. In this regard, nanomaterials, particularly, those combining two or even several constituting materials possessing dissimilar physicochemical (or even biological) properties, i.e., nanohybrid materials play a significant role. Nanoparticulate nanohybrids have gained a widespread reputation for prevention of viral crises, thanks to their promising antimicrobial properties as well as their potential to act as a carrier for vaccines. On the other hand, they can perform well as a photo-driven killer for viruses when they release reactive oxygen species (ROS) or photothermally damage the virus membrane. The nanofibers can also play a crucial protective role when integrated into face masks and personal protective equipment, particularly as hybridized with antiviral nanoparticles. In this draft, we review the antiviral nanohybrids that could potentially be applied to control, diagnose, and treat the consequences of COVID-19 pandemic. Considering the short age of this health problem, trivially the relevant technologies are not that many and are handful. Therefore, still progressing, older technologies with antiviral potential are also included and discussed. To conclude, nanohybrid nanomaterials with their high engineering potential and ability to inactivate pathogens including viruses will contribute decisively to the future of nanomedicine tackling the current and future pandemics.
1. Introduction
December 2019 was the onset of a new coronavirus pandemic in China that was then rapidly spread across the world. Two months later in February, the Coronavirus Study Group (CGS) of the International Committee on Virus Taxonomy (ICTV) designated the virus as SARS-CoV-2 and the caused disease was named as “coronoavirus disease 2019” (COVID-19) by the Director General of the World Health Organization (WHO) [1]. In March 2020, the WHO announced that the COVID-19 outbreak is a pandemic [1]. This rapidly spreading pandemic has affected all around the world, ending up with the infection of ~187 millions of people and the death of ~4.04 million of the infected cases (the statistics were obtained from worldometer.info on 10 July 2021).
Cough, fever, and fatigue are the main symptoms of the coronavirus disease and commonly seen in 68.7%, 85.6%, and 39.4% of the patients, respectively. The comorbidities including diabetes, hypertension, and coronary heart disease have been proved to directly affect the severity of the disease [2]. As reported lately [3,4,5,6], a number of patients suffering from COVID-19 shows damage not only in the respiratory system but also in kidney, heart, brain (encephalitis), and eye (conjunctivitis). Such adverse health consequences necessitate prompt development of vaccines, drugs, and medical tools that can effectively fight COVID-19. In this regard, nanomedicine and nanotechnology can offer many opportunities, as have done already throughout the history of novel medicine.
3. Conclusions and Future Perspective
The Covid-19 pandemic made us all encounter unpredicted challenges. Despite loss of many humans and irreversible damages to human society, this crisis had a second face of coin. It made us think how to prepare ourselves in the future for other likely virus pandemics. It taught us how to progress in science despite time and resource limitation and how to further consider the natural sources in dealing with such a crisis. Bioinspiration and employment of natural materials to cope with a natural crisis have advanced notably. Now, we mimic the structure and function of viruses to fight with them. The newly emerged vaccine systems that are in fact biohybrids in nanoscale are one of the mind-blowing achievements of human kind that was driven by surge of viral infections across the world. Now, we know that in the future we need multifunctional, bioinspired weapons against viruses. To meet this need, materials science and biology are coupled to generate a new generation of multifunctional and environmentally friendly nanohybrids that not only inactivate viruses, but also prevent their transmission and surface adhesion. Antiviral coatings are crucial to prevent the spread of viruses. On the other hand, the packaging materials that can show antimicrobial activity are highly demanded for disinfection of microorganisms. Furthermore, for the purpose of development of antiviral fabrics for PPE and household masks, antiviral nanohybrids will play a critical role.
In a broader perspective, we must seek advanced approaches guaranteeing health, but with consideration of the “One Health” concept, that stresses on the fact that the well-being of humans is tightly connected to that of other creatures and environment [1]. To tackle this intricate challenge, multidisciplinary researches involving scientists with complementing expertise are highly needed. The current crisis should be thought as a great opportunity to make us think about our globalized world and encourage us to take multi/interdisciplinary methodology more seriously. In this regard, transversal disciplines should be involved and the knowledge exchange and diversity in scientific point of views should be considered vital to create new, advanced scientific solutions. In this context, nanotechnology, particularly involving multifunctional nanohybrids, is a fertile area wherein researchers with different backgrounds can cooperate to address the complex problems. This frontline discipline is needed now more than ever to create new pillars toward resolving the current global public health issues, to weaponize us for the likely upcoming health challenges (e.g., infectious diseases), and to help us further consider sustainable scientific solutions.
Author Contributions
Conceptualization, S.H.; investigation, S.H., Q.L. and D.K.; writing—original draft preparation, S.H. and Q.L.; writing—review and editing, S.H.; supervision, S.H. All authors have read and agreed to the published version of the manuscript.
Funding
This research received no external funding.
Conflicts of Interest
The authors declare no conflict of interest.
References
- Weiss, C.; Carriere, M.; Fusco, L.; Capua, I.; Regla-Nava, J.A.; Pasquali, M.; Scott, J.A.; Vitale, F.; Unal, M.A.; Mattevi, C. Toward nanotechnology-enabled approaches against the COVID-19 pandemic. ACS Nano 2020, 14, 6383–6406. [Google Scholar] [CrossRef]
- Lovato, A.; De Filippis, C. Clinical presentation of COVID-19: A systematic review focusing on upper airway symptoms. Ear Nose Throat J. 2020, 99, 569–576. [Google Scholar] [CrossRef] [PubMed] [Green Version]
- Bansal, M. Cardiovascular disease and COVID-19. Diabetes Metab. Syndr. Clin. Res. Rev. 2020, 14, 247–250. [Google Scholar] [CrossRef]
- Rabb, H. Kidney diseases in the time of COVID-19: Major challenges to patient care. J. Clin. Investig. 2020, 130, 2749–2751. [Google Scholar] [CrossRef] [PubMed] [Green Version]
- Seah, I.; Agrawal, R. Can the coronavirus disease 2019 (COVID-19) affect the eyes? A review of coronaviruses and ocular implications in humans and animals. Ocul. Immunol. Inflamm. 2020, 28, 391–395. [Google Scholar] [CrossRef] [PubMed]
- Wu, Y.; Xu, X.; Chen, Z.; Duan, J.; Hashimoto, K.; Yang, L.; Liu, C.; Yang, C. Nervous system involvement after infection with COVID-19 and other coronaviruses. Brain Behav. Immun. 2020, 87, 18–22. [Google Scholar] [CrossRef] [PubMed]
- Campos, E.V.; Pereira, A.E.; De Oliveira, J.L.; Carvalho, L.B.; Guilger-Casagrande, M.; De Lima, R.; Fraceto, L.F. How can nanotechnology help to combat COVID-19? Opportunities and urgent need. J. Nanobiotechnol. 2020, 18, 1–23. [Google Scholar] [CrossRef]
- Homaeigohar, S.; Elbahri, M. Switchable Plasmonic Nanocomposites. Adv. Opt. Mater. 2019, 7, 1801101. [Google Scholar] [CrossRef] [Green Version]
- Homaeigohar, S.; Boccaccini, A.R. Antibacterial biohybrid nanofibers for wound dressings. Acta Biomater. 2020, 107, 25–49. [Google Scholar] [CrossRef] [PubMed]
- Homaeigohar, S.; Botcha, N.K.; Zarie, E.S.; Elbahri, M. Ups and Downs of Water Photodecolorization by Nanocomposite Polymer Nanofibers. Nanomaterials 2019, 9, 250. [Google Scholar] [CrossRef] [Green Version]
- Joe, Y.H.; Park, D.H.; Hwang, J. Evaluation of Ag nanoparticle coated air filter against aerosolized virus: Anti-viral efficiency with dust loading. J. Hazard. Mater. 2016, 301, 547–553. [Google Scholar] [CrossRef] [PubMed]
- Tebyetekerwa, M.; Xu, Z.; Yang, S.; Ramakrishna, S. Electrospun nanofibers-based face masks. Adv. Fiber Mater. 2020, 2, 161–166. [Google Scholar] [CrossRef]
- O’Dowd, K.; Nair, K.M.; Forouzandeh, P.; Mathew, S.; Grant, J.; Moran, R.; Bartlett, J.; Bird, J.; Pillai, S.C. Face masks and respirators in the fight against the COVID-19 pandemic: A review of current materials, advances and future perspectives. Materials 2020, 13, 3363. [Google Scholar] [CrossRef] [PubMed]
- Akduman, C.; Kumbasar, E.P.A. Nanofibers in face masks and respirators to provide better protection. In Proceedings of the IOP Conference Series: Materials Science and Engineering; IOP Publishing: Bristol, UK, 2018; Volume 460, p. 012013. [Google Scholar]
- Ramaseshan, R.; Sundarrajan, S.; Liu, Y.; Barhate, R.S.; Lala, N.L.; Ramakrishna, S. Functionalized polymer nanofibre membranes for protection from chemical warfare stimulants. Nanotechnology 2006, 17, 2947–2953. [Google Scholar] [CrossRef]
- Tong, H.W.; Kwok, S.K.C.; Kwok, H.C. Protective masks with coating comprising different electrospun fibers interweaved with each other, formulations forming the same, and method of producing thereof. U.S. Patent 10,201,198, 12 February 2019. [Google Scholar]
- Prather, K.A.; Wang, C.C.; Schooley, R.T. Reducing transmission of SARS-CoV-2. Science 2020, 368, 1422–1424. [Google Scholar] [CrossRef] [PubMed]
- Zhang, Z.; Ji, D.; He, H.; Ramakrishna, S. Electrospun ultrafine fibers for advanced face masks. Mater. Sci. Eng. R. Rep. 2021, 143, 100594. [Google Scholar] [CrossRef]
- Suen, L.; Guo, Y.; Ho, S.; Au-Yeung, C.; Lam, S. Comparing mask fit and usability of traditional and nanofibre N95 filtering facepiece respirators before and after nursing procedures. J. Hosp. Infect. 2020, 104, 336–343. [Google Scholar] [CrossRef] [PubMed] [Green Version]
- Xianhua, Z.; Xiangwei, F.; Bin, Y.; Fan, L.; Lina, C.; Cengceng, Z. Study on Preparation and Properties of PVA/AGNPS Composite Nanofiber Mask Material. Dig. J. Nanomater. Biostruct. 2020, 15, 299–309. [Google Scholar]
- Zhang, Z.; El-Moghazy, A.Y.; Wisuthiphaet, N.; Nitin, N.; Castillo, D.; Murphy, B.G.; Sun, G. Daylight-induced antibacterial and antiviral nanofibrous membranes containing vitamin K derivatives for personal protective equipment. ACS Appl. Mater. Interfaces 2020, 12, 49416–49430. [Google Scholar] [CrossRef] [PubMed]
- Shin, M.D.; Shukla, S.; Chung, Y.H.; Beiss, V.; Chan, S.K.; Ortega-Rivera, O.A.; Wirth, D.M.; Chen, A.; Sack, M.; Pokorski, J.K. COVID-19 vaccine development and a potential nanomaterial path forward. Nat. Nanotechnol. 2020, 15, 646–655. [Google Scholar] [CrossRef] [PubMed]
- Rabinovich, N.R.; McInnes, P.; Klein, D.L.; Hall, B.F. Vaccine technologies: View to the future. Science 1994, 265, 1401–1404. [Google Scholar] [CrossRef] [PubMed]
- MacGregor, R.R.; Boyer, J.D.; Ugen, K.E.; Lacy, K.E.; Gluckman, S.J.; Bagarazzi, M.L.; Chattergoon, M.A.; Baine, Y.; Higgins, T.J.; Ciccarelli, R.B. First human trial of a DNA-based vaccine for treatment of human immunodeficiency virus type 1 infection: Safety and host response. J. Infect. Dis. 1998, 178, 92–100. [Google Scholar] [CrossRef] [PubMed] [Green Version]
- Norell, H.; Poschke, I.; Charo, J.; Wei, W.Z.; Erskine, C.; Piechocki, M.P.; Knutson, K.L.; Bergh, J.; Lidbrink, E.; Kiessling, R. Vaccination with a plasmid DNA encoding HER-2/neu together with low doses of GM-CSF and IL-2 in patients with metastatic breast carcinoma: A pilot clinical trial. J. Transl. Med. 2010, 8, 1–11. [Google Scholar] [CrossRef] [Green Version]
- Rinaldi, M.; Signori, E.; Rosati, P.; Cannelli, G.; Parrella, P.; Iannace, E.; Monego, G.; Ciafrè, S.A.; Farace, M.G.; Iurescia, S. Feasibilty of in utero DNA vaccination following naked gene transfer into pig fetal muscle: Transgene expression, immunity and safety. Vaccine 2006, 24, 4586–4591. [Google Scholar] [CrossRef]
- Trimble, C.L.; Peng, S.; Kos, F.; Gravitt, P.; Viscidi, R.; Sugar, E.; Pardoll, D.; Wu, T. A phase I trial of a human papillomavirus DNA vaccine for HPV16+ cervical intraepithelial neoplasia 2/3. Clin. Cancer Res. 2009, 15, 361–367. [Google Scholar] [CrossRef] [Green Version]
- Bagarazzi, M.L.; Yan, J.; Morrow, M.P.; Shen, X.; Parker, R.L.; Lee, J.C.; Giffear, M.; Pankhong, P.; Khan, A.S.; Broderick, K.E. Immunotherapy against HPV16/18 generates potent TH1 and cytotoxic cellular immune responses. Sci. Transl. Med. 2012, 4, ra138–ra155. [Google Scholar] [CrossRef] [Green Version]
- Zhang, M.; Hong, Y.; Chen, W.; Wang, C. Polymers for DNA vaccine delivery. ACS Biomater. Sci. Eng. 2017, 3, 108–125. [Google Scholar] [CrossRef]
- Lim, M.; Badruddoza, A.Z.M.; Firdous, J.; Azad, M.; Mannan, A.; Al-Hilal, T.A.; Cho, C.-S.; Islam, M.A. Engineered nanodelivery systems to improve DNA vaccine technologies. Pharmaceutics 2020, 12, 30. [Google Scholar] [CrossRef] [Green Version]
- Zhao, K.; Zhang, Y.; Zhang, X.; Shi, C.; Wang, X.; Wang, X.; Jin, Z.; Cui, S. Chitosan-coated poly (lactic-co-glycolic) acid nanoparticles as an efficient delivery system for Newcastle disease virus DNA vaccine. Int. J. Nanomed. 2014, 9, 4609. [Google Scholar] [CrossRef] [PubMed] [Green Version]
- Farris, E.; Brown, D.M.; Ramer-Tait, A.E.; Pannier, A.K. Chitosan-zein nano-in-microparticles capable of mediating in vivo transgene expression following oral delivery. J. Control. Release 2017, 249, 150–161. [Google Scholar] [CrossRef] [PubMed] [Green Version]
- Layek, B.; Lipp, L.; Singh, J. APC targeted micelle for enhanced intradermal delivery of hepatitis B DNA vaccine. J. Control. Release 2015, 207, 143–153. [Google Scholar] [CrossRef]
- Tenchov, R.; Bird, R.; Curtze, A.E.; Zhou, Q. Lipid Nanoparticles—From Liposomes to mRNA Vaccine Delivery, a Landscape of Research Diversity and Advancement. ACS Nano 2021. [Google Scholar] [CrossRef]
- Pardi, N.; Hogan, M.J.; Porter, F.W.; Weissman, D. mRNA vaccines—A new era in vaccinology. Nat. Rev. Drug Discov. 2018, 17, 261–279. [Google Scholar] [CrossRef] [Green Version]
- Elia, U.; Ramishetti, S.; Rosenfeld, R.; Dammes, N.; Bar-Haim, E.; Naidu, G.S.; Makdasi, E.; Yahalom-Ronen, Y.; Tamir, H.; Paran, N. Design of SARS-CoV-2 hFc-conjugated receptor-binding domain mRNA vaccine delivered via lipid nanoparticles. ACS Nano 2021, 15, 9627–9637. [Google Scholar] [CrossRef]
- Zhuang, X.; Qi, Y.; Wang, M.; Yu, N.; Nan, F.; Zhang, H.; Tian, M.; Li, C.; Lu, H.; Jin, N. mRNA vaccines encoding the HA protein of influenza A H1N1 virus delivered by cationic lipid nanoparticles induce protective immune responses in mice. Vaccines 2020, 8, 123. [Google Scholar] [CrossRef] [Green Version]
- Gómez-Aguado, I.; Rodríguez-Castejón, J.; Vicente-Pascual, M.; Rodríguez-Gascón, A.; Solinís, M.Á.; del Pozo-Rodríguez, A. Nanomedicines to deliver mRNA: State of the art and future perspectives. Nanomaterials 2020, 10, 364. [Google Scholar] [CrossRef] [Green Version]
- Ross, K.; Senapati, S.; Alley, J.; Darling, R.; Goodman, J.; Jefferson, M.; Uz, M.; Guo, B.; Yoon, K.-J.; Verhoeven, D. Single dose combination nanovaccine provides protection against influenza A virus in young and aged mice. Biomater. Sci. 2019, 7, 809–821. [Google Scholar] [CrossRef] [PubMed] [Green Version]
- Patterson, D.P.; Rynda-Apple, A.; Harmsen, A.L.; Harmsen, A.G.; Douglas, T. Biomimetic antigenic nanoparticles elicit controlled protective immune response to influenza. ACS Nano 2013, 7, 3036–3044. [Google Scholar] [CrossRef] [PubMed] [Green Version]
- Bachmann, M.F.; Jennings, G.T. Vaccine delivery: A matter of size, geometry, kinetics and molecular patterns. Nature Rev. Immunology 2010, 10, 787–796. [Google Scholar] [CrossRef] [PubMed]
- Herzog, C.; Hartmann, K.; Künzi, V.; Kürsteiner, O.; Mischler, R.; Lazar, H.; Glück, R. Eleven years of Inflexal® V—A virosomal adjuvanted influenza vaccine. Vaccine 2009, 27, 4381–4387. [Google Scholar] [CrossRef] [PubMed]
- Wang, S.; Qin, L.; Yamankurt, G.; Skakuj, K.; Huang, Z.; Chen, P.-C.; Dominguez, D.; Lee, A.; Zhang, B.; Mirkin, C.A. Rational vaccinology with spherical nucleic acids. Proc. Natl. Acad. Sci. USA 2019, 116, 10473–10481. [Google Scholar] [CrossRef] [PubMed] [Green Version]
- Smith, D.M.; Simon, J.K.; Baker Jr, J.R. Applications of nanotechnology for immunology. Nat. Rev. Immunol. 2013, 13, 592–605. [Google Scholar] [CrossRef]
- Hooshmand, S.; Kargozar, S.; Ghorbani, A.; Darroudi, M.; Keshavarz, M.; Baino, F.; Kim, H.-W. Biomedical waste management by using nanophotocatalysts: The need for new options. Materials 2020, 13, 3511. [Google Scholar] [CrossRef] [PubMed]
- Hoornweg, D.; Bhada-Tata, P. What a Waste: A Global Review of Solid Waste Management; World Bank: Washington, DC, USA, 2012. [Google Scholar]
- Hisaindee, S.; Meetani, M.; Rauf, M. Application of LC-MS to the analysis of advanced oxidation process (AOP) degradation of dye products and reaction mechanisms. TrAC Trends Anal. Chem. 2013, 49, 31–44. [Google Scholar] [CrossRef]
- Mondal, K.; Sharma, A. Recent advances in the synthesis and application of photocatalytic metal–metal oxide core–shell nanoparticles for environmental remediation and their recycling process. RSC Adv. 2016, 6, 83589–83612. [Google Scholar] [CrossRef]
- Ahmadpour, N.; Sayadi, M.H.; Homaeigohar, S. A hierarchical Ca/TiO 2/NH 2-MIL-125 nanocomposite photocatalyst for solar visible light induced photodegradation of organic dye pollutants in water. RSC Adv. 2020, 10, 29808–29820. [Google Scholar] [CrossRef]
- Ghadimi, M.; Zangenehtabar, S.; Homaeigohar, S. An overview of the water remediation potential of nanomaterials and their ecotoxicological impacts. Water 2020, 12, 1150. [Google Scholar] [CrossRef] [Green Version]
- Homaeigohar, S. The nanosized dye adsorbents for water treatment. Nanomaterials 2020, 10, 295. [Google Scholar] [CrossRef] [Green Version]
- Sunada, K.; Watanabe, T.; Hashimoto, K. Bactericidal activity of copper-deposited TiO2 thin film under weak UV light illumination. Environ. Sci. Technol. 2003, 37, 4785–4789. [Google Scholar] [CrossRef]
- Sapiña, M.; Jimenez-Relinque, E.; Nevshupa, R.; Roman, E.; Castellote, M. Degradation of pollen on nanofunctionalized photocatalytic materials. J. Chem. Technol. Biotechnol. 2017, 92, 210–216. [Google Scholar] [CrossRef]
- Guerrini, G.L. Photocatalysis and virus. From theory to applications. J. Photocatal. 2021, 2, 25–34. [Google Scholar] [CrossRef]
- Zhang, C.; Li, Y.; Shuai, D.; Shen, Y.; Wang, D. Progress and challenges in photocatalytic disinfection of waterborne viruses: A review to fill current knowledge gaps. Chem. Eng. J. 2019, 355, 399–415. [Google Scholar] [CrossRef]
- Gomes, J.; Matos, A.; Gmurek, M.; Quinta-Ferreira, R.M.; Martins, R.C. Ozone and photocatalytic processes for pathogens removal from water: A review. Catalysts 2019, 9, 46. [Google Scholar] [CrossRef] [Green Version]
- Gerrity, D.; Ryu, H.; Crittenden, J.; Abbaszadegan, M. Photocatalytic inactivation of viruses using titanium dioxide nanoparticles and low-pressure UV light. J. Environ. Sci. Health Part A 2008, 43, 1261–1270. [Google Scholar] [CrossRef]
- Ren, H.; Koshy, P.; Chen, W.-F.; Qi, S.; Sorrell, C.C. Photocatalytic materials and technologies for air purification. J. Hazard. Mater. 2017, 325, 340–366. [Google Scholar] [CrossRef]
- Kannan, K.; Sivasubramanian, D.; Seetharaman, P.; Sivaperumal, S. Structural and biological properties with enhanced photocatalytic behaviour of CdO-MgO nanocomposite by microwave-assisted method. Optik 2020, 204, 164221. [Google Scholar] [CrossRef]
- Magdalane, C.M.; Kaviyarasu, K.; Vijaya, J.J.; Siddhardha, B.; Jeyaraj, B. Photocatalytic activity of binary metal oxide nanocomposites of CeO2/CdO nanospheres: Investigation of optical and antimicrobial activity. J. Photochem. Photobiol. B Biol. 2016, 163, 77–86. [Google Scholar] [CrossRef]
- Suganya, M.; Balu, A.; Prabha, D.; Anitha, S.; Balamurugan, S.; Srivind, J. PbS–SnO2 nanocomposite with enhanced magnetic, photocatalytic and antifungal properties. J. Mater. Sci. Mater. Electron. 2018, 29, 1065–1074. [Google Scholar] [CrossRef]
- Karthik, K.; Dhanuskodi, S.; Gobinath, C.; Prabukumar, S.; Sivaramakrishnan, S. Nanostructured CdO-NiO composite for multifunctional applications. J. Phys. Chem. Solids 2018, 112, 106–118. [Google Scholar] [CrossRef]
- Karthik, K.; Dhanuskodi, S.; Gobinath, C.; Sivaramakrishnan, S. Microwave-assisted synthesis of CdO–ZnO nanocomposite and its antibacterial activity against human pathogens. Spectrochim. Acta Part. A Mol. Biomol. Spectrosc. 2015, 139, 7–12. [Google Scholar] [CrossRef]
- Anitha, S.; Suganya, M.; Prabha, D.; Srivind, J.; Balamurugan, S.; Balu, A. Synthesis and characterization of NiO-CdO composite materials towards photoconductive and antibacterial applications. Mater. Chem. Phys. 2018, 211, 88–96. [Google Scholar] [CrossRef]
- Maruthai, J.; Muthukumarasamy, A.; Baskaran, B. Optical, biological and catalytic properties of ZnO/MgO nanocomposites derived via Musa paradisiaca bract extract. Ceram. Int. 2018, 44, 13152–13160. [Google Scholar] [CrossRef]
- Alla, S.; Verma, A.; Kumar, V.; Mandal, R.; Sinha, I.; Prasad, N. Solvothermal synthesis of CuO–MgO nanocomposite particles and their catalytic applications. RSC Adv. 2016, 6, 61927–61933. [Google Scholar] [CrossRef]
- Sayadi, M.H.; Ahmadpour, N.; Homaeigohar, S. Photocatalytic and Antibacterial Properties of Ag-CuFe2O4@ WO3 Magnetic Nanocomposite. Nanomaterials 2021, 11, 298. [Google Scholar] [CrossRef] [PubMed]
- Qi, K.; Cheng, B.; Yu, J.; Ho, W. Review on the improvement of the photocatalytic and antibacterial activities of ZnO. J. Alloy. Compd. 2017, 727, 792–820. [Google Scholar] [CrossRef]
- Valasek, M.A.; Repa, J.J. The power of real-time PCR. Adv. Physiol. Educ. 2005, 29, 151–159. [Google Scholar] [CrossRef]
- Mackay, I.M.; Arden, K.E.; Nitsche, A. Real-time PCR in virology. Nucleic Acids Res. 2002, 30, 1292–1305. [Google Scholar] [CrossRef] [PubMed] [Green Version]
- Mitamura, K.; Shimizu, H.; Yamazaki, M.; Ichikawa, M.; Nagai, K.; Katada, J.; Wada, A.; Kawakami, C.; Sugaya, N. Clinical evaluation of highly sensitive silver amplification immunochromatography systems for rapid diagnosis of influenza. J. Virol. Methods 2013, 194, 123–128. [Google Scholar] [CrossRef] [PubMed]
- Sasaki, T.; Kubota-Koketsu, R.; Takei, M.; Hagihara, T.; Iwamoto, S.; Murao, T.; Sawami, K.; Fukae, D.; Nakamura, M.; Nagata, E. Reliability of a newly-developed immunochromatography diagnostic kit for pandemic influenza A/H1N1pdm virus: Implications for drug administration. PLoS ONE 2012, 7, e50670. [Google Scholar]
- Tsang, M.-K.; Ye, W.; Wang, G.; Li, J.; Yang, M.; Hao, J. Ultrasensitive detection of Ebola virus oligonucleotide based on upconversion nanoprobe/nanoporous membrane system. ACS Nano 2016, 10, 598–605. [Google Scholar] [CrossRef]
- Wu, Z.; Zeng, T.; Guo, W.-J.; Bai, Y.-Y.; Pang, D.-W.; Zhang, Z.-L. Digital single virus immunoassay for ultrasensitive multiplex avian influenza virus detection based on fluorescent magnetic multifunctional nanospheres. ACS Appl. Mater. Interfaces 2019, 11, 5762–5770. [Google Scholar] [CrossRef] [PubMed]
- Nasrin, F.; Chowdhury, A.D.; Takemura, K.; Kozaki, I.; Honda, H.; Adegoke, O.; Park, E.Y. Fluorometric virus detection platform using quantum dots-gold nanocomposites optimizing the linker length variation. Anal. Chim. Acta 2020, 1109, 148–157. [Google Scholar] [CrossRef]
- Chowdhury, A.D.; Nasrin, F.; Gangopadhyay, R.; Ganganboina, A.B.; Takemura, K.; Kozaki, I.; Honda, H.; Hara, T.; Abe, F.; Park, S. Controlling distance, size and concentration of nanoconjugates for optimized LSPR based biosensors. Biosens. Bioelectron. 2020, 170, 112657. [Google Scholar] [CrossRef] [PubMed]
- Tancharoen, C.; Sukjee, W.; Thepparit, C.; Jaimipuk, T.; Auewarakul, P.; Thitithanyanont, A.; Sangma, C. Electrochemical biosensor based on surface imprinting for zika virus detection in serum. ACS Sens. 2018, 4, 69–75. [Google Scholar] [CrossRef] [PubMed]
- Chowdhury, A.D.; Takemura, K.; Li, T.-C.; Suzuki, T.; Park, E.Y. Electrical pulse-induced electrochemical biosensor for hepatitis E virus detection. Nat. Commun. 2019, 10, 1–12. [Google Scholar] [CrossRef] [Green Version]
- Kuilla, T.; Bhadra, S.; Yao, D.; Kim, N.H.; Bose, S.; Lee, J.H. Recent advances in graphene based polymer composites. Prog. Polym. Sci. 2010, 35, 1350–1375. [Google Scholar] [CrossRef]
- Zainudin, A.A.; Fen, Y.W.; Yusof, N.A.; Omar, N.A.S. Structural, optical and sensing properties of ionophore doped graphene based bionanocomposite thin film. Optik 2017, 144, 308–315. [Google Scholar] [CrossRef]
- Suvarnaphaet, P.; Pechprasarn, S. Graphene-based materials for biosensors: A review. Sensors 2017, 17, 2161. [Google Scholar] [CrossRef] [PubMed] [Green Version]
- Balandin, A.A. Thermal properties of graphene and nanostructured carbon materials. Nat. Mater. 2011, 10, 569–581. [Google Scholar] [CrossRef] [PubMed] [Green Version]
- Homaeigohar, S.; Elbahri, M. Graphene membranes for water desalination. NPG Asia Mater. 2017, 9, e427. [Google Scholar] [CrossRef] [Green Version]
- Gilje, S.; Han, S.; Wang, M.; Wang, K.L.; Kaner, R.B. A chemical route to graphene for device applications. Nano Lett. 2007, 7, 3394–3398. [Google Scholar] [CrossRef]
- Xing, F.; Liu, Z.-B.; Deng, Z.-C.; Kong, X.-T.; Yan, X.-Q.; Chen, X.-D.; Ye, Q.; Zhang, C.-P.; Chen, Y.-S.; Tian, J.-G. Sensitive real-time monitoring of refractive indexes using a novel graphene-based optical sensor. Sci. Rep. 2012, 2, 1–7. [Google Scholar] [CrossRef] [Green Version]
- Navaee, A.; Salimi, A. Efficient amine functionalization of graphene oxide through the Bucherer reaction: An extraordinary metal-free electrocatalyst for the oxygen reduction reaction. RSC Adv. 2015, 5, 59874–59880. [Google Scholar] [CrossRef]
- Zhu, J.; Ye, Z.; Fan, X.; Wang, H.; Wang, Z.; Chen, B. A highly sensitive biosensor based on Au NPs/rGO-PAMAM-Fc nanomaterials for detection of cholesterol. Int. J. Nanomed. 2019, 14, 835. [Google Scholar] [CrossRef] [PubMed] [Green Version]
- Bharti, J.P.; Prajapati, S.; Jaiswal, M.K.; Yadav, R.D. Dendrimer multifunctional nano-device: A review. Int. J. Pharm. Sci. Res. 2011, 2, 1947. [Google Scholar]
- Omar, N.A.S.; Fen, Y.W.; Abdullah, J.; Sadrolhosseini, A.R.; Mustapha Kamil, Y.; Fauzi, N.I.M.; Hashim, H.S.; Mahdi, M.A. Quantitative and selective surface plasmon resonance response based on a reduced graphene oxide-polyamidoamine nanocomposite for detection of dengue virus e-proteins. Nanomaterials 2020, 10, 569. [Google Scholar] [CrossRef] [PubMed] [Green Version]
- Anik, Ü.; Tepeli, Y.; Sayhi, M.; Nsiri, J.; Diouani, M.F. Towards the electrochemical diagnostic of influenza virus: Development of a graphene—Au hybrid nanocomposite modified influenza virus biosensor based on neuraminidase activity. Analyst 2018, 143, 150–156. [Google Scholar] [CrossRef]
- Caygill, R.L.; Blair, G.E.; Millner, P.A. A review on viral biosensors to detect human pathogens. Anal. Chim. Acta 2010, 681, 8–15. [Google Scholar] [CrossRef]
- Shen, Q.; Han, L.; Fan, G.; Zhang, J.-R.; Jiang, L.; Zhu, J.-J. “Signal-on” photoelectrochemical biosensor for sensitive detection of human T-cell lymphotropic virus type II DNA: Dual signal amplification strategy integrating enzymatic amplification with terminal deoxynucleotidyl transferase-mediated extension. Anal. Chem. 2015, 87, 4949–4956. [Google Scholar] [CrossRef]
- Cheng, W.; Dong, S.; Wang, E. Gold nanoparticles as fine tuners of electrochemical properties of the electrode/solution interface. Langmuir 2002, 18, 9947–9952. [Google Scholar] [CrossRef]
- Takemura, K.; Ganganboina, A.B.; Khoris, I.M.; Chowdhury, A.D.; Park, E.Y. Plasmon Nanocomposite-Enhanced Optical and Electrochemical Signals for Sensitive Virus Detection. ACS Sens. 2021, 6, 2605–2612. [Google Scholar] [CrossRef] [PubMed]
- Kim, J.-W.; Kim, M.; Lee, K.K.; Chung, K.H.; Lee, C.-S. Effects of Graphene Oxide-Gold Nanoparticles Nanocomposite on Highly Sensitive Foot-and-Mouth Disease Virus Detection. Nanomaterials 2020, 10, 1921. [Google Scholar] [CrossRef] [PubMed]
- Li, H.; Rothberg, L. Colorimetric detection of DNA sequences based on electrostatic interactions with unmodified gold nanoparticles. Proc. Natl. Acad. Sci. USA 2004, 101, 14036–14039. [Google Scholar] [CrossRef] [PubMed] [Green Version]
- Kumar, P.; Kumar, B.; Rajput, R.; Saxena, L.; Banerjea, A.C.; Khanna, M. Cross-protective effect of antisense oligonucleotide developed against the common 3′ NCR of influenza A virus genome. Mol. Biotechnol. 2013, 55, 203–211. [Google Scholar] [CrossRef] [PubMed]
- Jain, B.; Jain, A. Taming influenza virus: Role of antisense technology. Curr. Mol. Med. 2015, 15, 433–445. [Google Scholar] [CrossRef]
- Levina, A.; Repkova, M.; Shikina, N.; Ismagilov, Z.; Kupryushkin, M.; Pavlova, A.; Mazurkova, N.; Pyshnyi, D.; Zarytova, V. Pronounced therapeutic potential of oligonucleotides fixed on inorganic nanoparticles against highly pathogenic H5N1 influenza A virus in vivo. Eur. J. Pharm. Biopharm. 2021, 162, 92–98. [Google Scholar] [CrossRef] [PubMed]
- Stiver, G. The treatment of influenza with antiviral drugs. CMAJ 2003, 168, 49–57. [Google Scholar]
- Wickstrom, E. DNA and RNA derivatives to optimize distribution and delivery. Adv. Drug Deliv. Rev. 2015, 87, 25–34. [Google Scholar] [CrossRef] [Green Version]
- Boisguérin, P.; Deshayes, S.; Gait, M.J.; O’Donovan, L.; Godfrey, C.; Betts, C.A.; Wood, M.J.; Lebleu, B. Delivery of therapeutic oligonucleotides with cell penetrating peptides. Adv. Drug Deliv. Rev. 2015, 87, 52–67. [Google Scholar] [CrossRef]
- Chen, S.; Hao, X.; Liang, X.; Zhang, Q.; Zhang, C.; Zhou, G.; Shen, S.; Jia, G.; Zhang, J. Inorganic nanomaterials as carriers for drug delivery. J. Biomed. Nanotechnol. 2016, 12, 1–27. [Google Scholar] [CrossRef]
- Juliano, R.; Carver, K. Cellular uptake and intracellular trafficking of oligonucleotides. Adv. Drug Deliv. Rev. 2015, 87, 35–45. [Google Scholar] [CrossRef] [Green Version]
- Levina, A.; Ismagilov, Z.; Repkova, M.; Shatskaya, N.; Shikina, N.; Tusikov, F.; Zarytova, V. Nanocomposites consisting of titanium dioxide nanoparticles and oligonucleotides. J. Nanosci. Nanotechnol. 2012, 12, 1812–1820. [Google Scholar] [CrossRef] [PubMed]
- Levina, A.S.; Repkova, M.N.; Mazurkova, N.A.; Zarytova, V.F. Nanoparticle-mediated nonviral DNA delivery for effective inhibition of influenza a viruses in cells. IEEE Trans. Nanotechnol. 2016, 15, 248–254. [Google Scholar] [CrossRef]
- Pletnev, D.; Evdokimov, A.; Belanov, E.; Malygin, E.; Balachnin, S.; Serova, O.; Zinoviev, V.; Zarytova, V.; Levina, A.; Repkova, M. Check of antiviral activity of nanocomposites with active check of antiviral activity of drugs based on nanocomposites, which contained oligonucleotides for direct splitting viral genome of influenza virus type A. Antivir. Res. 2008, 78, A46. [Google Scholar] [CrossRef]
- Repkova, M.; Levina, A.; Chelobanov, B.; Ismagilov, Z.; Shatskaya, N.; Baiborodin, S.; Filippova, E.; Mazurkova, N.; Zarytova, V. Efficient inhibition of influenza A viral replication in cells by deoxyribozymes delivered by nanocomposites. Int. J. Antimicrob. Agents 2017, 49, 703–708. [Google Scholar] [CrossRef]
- World Health Organization. Hepatitis C. 2019. Available online: https://www.who.int/news-room/fact-sheets/detail/hepatitis-c (accessed on 15 July 2021).
- Elgharably, A.; Gomaa, A.I.; Crossey, M.M.; Norsworthy, P.J.; Waked, I.; Taylor-Robinson, S.D. Hepatitis C in Egypt–past, present, and future. Int. J. Gen. Med. 2017, 10, 1. [Google Scholar] [CrossRef] [PubMed]
- Tremblay, N.; Park, A.Y.; Lamarre, D. HCV NS3/4A protease inhibitors and the road to effective direct-acting antiviral therapies. In Hepatitis C Virus II; Springer: Berlin/Heidelberg, Germany, 2016; pp. 257–285. [Google Scholar]
- Boyd, S.; Harrington, P.; Komatsu, T.; Naeger, L.; Chan-Tack, K.; Murray, J.; Birnkrant, D.; Struble, K. HCV genotype 4, 5 and 6: Distribution of viral subtypes and sustained virologic response rates in clinical trials of approved direct-acting antiviral regimens. J. Viral Hepat. 2018, 25, 969–975. [Google Scholar] [CrossRef]
- Nafisi, S.; Roy, S.; Gish, R.; Manch, R.; Kohli, A. Defining the possibilities: Is short duration treatment of chronic hepatitis C genotype 1 with sofosbuvir-containing regimens likely to be as effective as current regimens? Expert Rev. Anti-Infect. Ther. 2016, 14, 41–56. [Google Scholar] [CrossRef] [PubMed]
- Jardim, A.C.G.; Shimizu, J.F.; Rahal, P.; Harris, M. Plant-derived antivirals against hepatitis c virus infection. Virol. J. 2018, 15, 1–13. [Google Scholar] [CrossRef] [Green Version]
- Khalaf, N.; White, D.; Kanwal, F.; Ramsey, D.; Mittal, S.; Tavakoli-Tabasi, S.; Kuzniarek, J.; El-Serag, H.B. Coffee and caffeine are associated with decreased risk of advanced hepatic fibrosis among patients with hepatitis C. Clin. Gastroenterol. Hepatol. 2015, 13, 1521–1531. [Google Scholar] [CrossRef]
- Assini, J.M.; Mulvihill, E.E.; Burke, A.C.; Sutherland, B.G.; Telford, D.E.; Chhoker, S.S.; Sawyez, C.G.; Drangova, M.; Adams, A.C.; Kharitonenkov, A. Naringenin prevents obesity, hepatic steatosis, and glucose intolerance in male mice independent of fibroblast growth factor 21. Endocrinology 2015, 156, 2087–2102. [Google Scholar] [CrossRef] [Green Version]
- Colpitts, C.C.; Schang, L.M.; Rachmawati, H.; Frentzen, A.; Pfaender, S.; Behrendt, P.; Brown, R.J.; Bankwitz, D.; Steinmann, J.; Ott, M. Turmeric curcumin inhibits entry of all hepatitis C virus genotypes into human liver cells. Gut 2014, 63, 1137–1149. [Google Scholar]
- Wei, Z.-Q.; Zhang, Y.-H.; Ke, C.-Z.; Chen, H.-X.; Ren, P.; He, Y.-L.; Hu, P.; Ma, D.-Q.; Luo, J.; Meng, Z.-J. Curcumin inhibits hepatitis B virus infection by down-regulating cccDNA-bound histone acetylation. World J. Gastroenterol. 2017, 23, 6252. [Google Scholar] [CrossRef] [PubMed]
- Moghadamtousi, S.Z.; Kadir, H.A.; Hassandarvish, P.; Tajik, H.; Abubakar, S.; Zandi, K. A Review on antibacterial, antiviral, and antifungal activity of curcumin. BioMed Res. Int. 2014, 2014, 1–12. [Google Scholar] [CrossRef] [PubMed]
- Pécheur, E.-I. Curcumin against hepatitis C virus infection: Spicing up antiviral therapies with ‘nutraceuticals’? Gut 2014, 63, 1035–1037. [Google Scholar] [CrossRef]
- Deljoo, S.; Rabiee, N.; Rabiee, M. Curcumin-hybrid nanoparticles in drug delivery system. Asian J. Nanosci. Mater. 2019, 2, 66–91. [Google Scholar]
- Jayakumar, R.; Selvamurugan, N.; Nair, S.; Tokura, S.; Tamura, H. Preparative methods of phosphorylated chitin and chitosan—An overview. Int. J. Biol. Macromol. 2008, 43, 221–225. [Google Scholar] [CrossRef] [PubMed]
- Sun, L.; Chen, Y.; Zhou, Y.; Guo, D.; Fan, Y.; Guo, F.; Zheng, Y.; Chen, W. Preparation of 5-fluorouracil-loaded chitosan nanoparticles and study of the sustained release in vitro and in vivo. Asian J. Pharm. Sci. 2017, 12, 418–423. [Google Scholar] [CrossRef]
- Loutfy, S.A.; El-Din, H.M.A.; Elberry, M.H.; Allam, N.G.; Hasanin, M.; Abdellah, A.M. Synthesis, characterization and cytotoxic evaluation of chitosan nanoparticles: In vitro liver cancer model. Adv. Nat. Sci. Nanosci. Nanotechnol. 2016, 7, 035008. [Google Scholar] [CrossRef]
- Akhtar, F.; Rizvi, M.M.A.; Kar, S.K. Oral delivery of curcumin bound to chitosan nanoparticles cured Plasmodium yoelii infected mice. Biotechnol. Adv. 2012, 30, 310–320. [Google Scholar] [CrossRef]
- Ramana, L.N.; Sharma, S.; Sethuraman, S.; Ranga, U.; Krishnan, U.M. Evaluation of chitosan nanoformulations as potent anti-HIV therapeutic systems. Biochim. Biophys. Acta Gen. Subj. 2014, 1840, 476–484. [Google Scholar] [CrossRef] [PubMed]
- Loutfy, S.A.; Elberry, M.H.; Farroh, K.Y.; Mohamed, H.T.; Mohamed, A.A.; Mohamed, E.B.; Faraag, A.H.I.; Mousa, S.A. Antiviral activity of chitosan nanoparticles encapsulating curcumin against hepatitis C virus genotype 4a in human hepatoma cell lines. Int. J. Nanomed. 2020, 15, 2699. [Google Scholar] [CrossRef] [PubMed] [Green Version]
- Wiehe, A.; O’Brien, J.M.; Senge, M.O. Trends and targets in antiviral phototherapy. Photochem. Photobiol. Sci. 2019, 18, 2565–2612. [Google Scholar] [CrossRef]
- Foote, C.S. Mechanisms of photosensitized oxidation. Science 1968, 162, 963–970. [Google Scholar] [CrossRef]
- Agostinis, P.; Berg, K.; Cengel, K.A.; Foster, T.H.; Girotti, A.W.; Gollnick, S.O.; Hahn, S.M.; Hamblin, M.R.; Juzeniene, A.; Kessel, D. Photodynamic therapy of cancer: An update. Cancer J. Clin. 2011, 61, 250–281. [Google Scholar] [CrossRef] [PubMed]
- Wainwright, M. Local treatment of viral disease using photodynamic therapy. Int. J. Antimicrob. Agents 2003, 21, 510–520. [Google Scholar] [CrossRef]
- Kharkwal, G.B.; Sharma, S.K.; Huang, Y.Y.; Dai, T.; Hamblin, M.R. Photodynamic therapy for infections: Clinical applications. Lasers Surg. Med. 2011, 43, 755–767. [Google Scholar] [CrossRef] [PubMed] [Green Version]
- Lim, M.E.; Lee, Y.-l.; Zhang, Y.; Chu, J.J.H. Photodynamic inactivation of viruses using upconversion nanoparticles. Biomaterials 2012, 33, 1912–1920. [Google Scholar] [CrossRef]
- Ambreen, G.; Duse, L.; Tariq, I.; Ali, U.; Ali, S.; Pinnapireddy, S.R.; Bette, M.; Bakowsky, U.; Mandic, R. Sensitivity of papilloma virus-associated cell lines to photodynamic therapy with curcumin-loaded liposomes. Cancers 2020, 12, 3278. [Google Scholar] [CrossRef] [PubMed]
- de Matos, B.T.L.; Buchaim, D.V.; Pomini, K.T.; Barbalho, S.M.; Guiguer, E.L.; Reis, C.H.B.; Bueno, C.R.d.S.; Cunha, M.R.d.; Pereira, E.d.S.B.M.; Buchaim, R.L. Photobiomodulation therapy as a possible new approach in COVID-19: A systematic review. Life 2021, 11, 580. [Google Scholar] [CrossRef] [PubMed]
- Anders, J.J.; Lanzafame, R.J.; Arany, P.R. Low-level light/laser therapy versus photobiomodulation therapy. Photomed. Laser Surg. 2015, 33, 183–184. [Google Scholar] [CrossRef] [PubMed] [Green Version]
- De Marchi, T.; Frâncio, F.; Ferlito, J.V.; Weigert, R.M.; de Oliveira, C.A.; Merlo, A.P.; Pandini, D.L.; Júnior, B.A.P.; Giovanella, D.F.; Tomazoni, S.S.; et al. Effects of photobiomodulation therapy combined with static magnetic field in severe COVID-19 patients requiring intubation: A pragmatic randomized placebo-controlled trial. J. Inflammation Res. 2021, 14, 3569–3585. [Google Scholar] [CrossRef] [PubMed]
- Lara, H.H.; Garza-Treviño, E.N.; Ixtepan-Turrent, L.; Singh, D.K. Silver nanoparticles are broad-spectrum bactericidal and virucidal compounds. J. Nanobiotechnol. 2011, 9, 1–8. [Google Scholar] [CrossRef] [PubMed] [Green Version]
- Fujimori, Y.; Sato, T.; Hayata, T.; Nagao, T.; Nakayama, M.; Nakayama, T.; Sugamata, R.; Suzuki, K. Novel antiviral characteristics of nanosized copper (I) iodide particles showing inactivation activity against 2009 pandemic H1N1 influenza virus. Appl. Environ. Microbiol. 2012, 78, 951–955. [Google Scholar] [CrossRef] [Green Version]
- Galdiero, S.; Falanga, A.; Vitiello, M.; Cantisani, M.; Marra, V.; Galdiero, M. Silver nanoparticles as potential antiviral agents. Molecules 2011, 16, 8894–8918. [Google Scholar] [CrossRef] [Green Version]
- Lara, H.H.; Ixtepan-Turrent, L.; Garza-Treviño, E.N.; Rodriguez-Padilla, C. PVP-coated silver nanoparticles block the transmission of cell-free and cell-associated HIV-1 in human cervical culture. J. Nanobiotechnol. 2010, 8, 1–11. [Google Scholar] [CrossRef]
- Papp, I.; Sieben, C.; Ludwig, K.; Roskamp, M.; Böttcher, C.; Schlecht, S.; Herrmann, A.; Haag, R. Inhibition of influenza virus infection by multivalent sialic-acid-functionalized gold nanoparticles. Small 2010, 6, 2900–2906. [Google Scholar] [CrossRef]
- Mallakpour, S.; Azadi, E.; Hussain, C.M. Recent breakthroughs of antibacterial and antiviral protective polymeric materials during COVID-19 pandemic and after pandemic: Coating, packaging, and textile applications. Curr. Opin. Colloid Interface Sci. 2021, 55, 101480. [Google Scholar] [CrossRef]
- Karagoz, S.; Kiremitler, N.B.; Sarp, G.; Pekdemir, S.; Salem, S.; Goksu, A.e.G.; Onses, M.S.; Sozdutmaz, I.; Sahmetlioglu, E.; Ozkara, E.S. Antibacterial, antiviral, and self-cleaning mats with sensing capabilities based on electrospun nanofibers decorated with ZnO nanorods and Ag nanoparticles for protective clothing applications. ACS Appl. Mater. Interfaces 2021, 13, 5678–5690. [Google Scholar] [CrossRef]
- Tremiliosi, G.C.; Simoes, L.G.P.; Minozzi, D.T.; Santos, R.I.; Vilela, D.C.; Durigon, E.L.; Machado, R.R.G.; Medina, D.S.; Ribeiro, L.K.; Rosa, I.L.V.; et al. Ag nanoparticles-based antimicrobial polycotton fabrics to prevent the transmission and spread of SARS-CoV-2. bioRxiv 2020, arXiv:2020.06.26.152520. [Google Scholar]
- Tran, N.-M.; Dufresne, M.; Helle, F.; Hoffmann, T.W.; François, C.; Brochot, E.; Paullier, P.; Legallais, C.; Duverlie, G.; Castelain, S. Alginate hydrogel protects encapsulated hepatic HuH-7 cells against hepatitis C virus and other viral infections. PLoS ONE 2014, 9, e109969. [Google Scholar] [CrossRef]
- Sanmartín-Santos, I.; Gandía-Llop, S.; Salesa, B.; Martí, M.; Lillelund Aachmann, F.; Serrano-Aroca, Á. Enhancement of antimicrobial activity of alginate films with a low amount of carbon nanofibers (0.1% w/w). Appl. Sci. 2021, 11, 2311. [Google Scholar] [CrossRef]
- Pietropaolo, V.; Seganti, L.; Marchetti, M.; Sinibaldi, L.; Orsi, N.; Nicoletti, R. Effect of natural and semisynthetic polymers on rabies virus infection in CER cells. Res. Virol. 1993, 144, 151–158. [Google Scholar] [CrossRef]
- Sano, Y. Antiviral activity of alginate against infection by tobacco mosaic virus. Carbohydr. Polym. 1999, 38, 183–186. [Google Scholar] [CrossRef]
- Homaeigohar, S.; Elbahri, M. An Amphiphilic, Graphitic Buckypaper Capturing Enzyme Biomolecules from Water. Water 2019, 11, 2. [Google Scholar] [CrossRef] [Green Version]
- Homaeigohar, S. amphiphilic oxygenated amorphous carbon-graphite buckypapers with gas sensitivity to polar and non-polar VOCs. Nanomaterials 2019, 9, 1343. [Google Scholar] [CrossRef] [PubMed] [Green Version]
- Homaeigohar, S.; Strunskus, T.; Strobel, J.; Kienle, L.; Elbahri, M. A flexible oxygenated carbographite nanofilamentous buckypaper as an amphiphilic membrane. Adv. Mater. Interfaces 2018, 5, 1800001. [Google Scholar] [CrossRef]
- Homaeigohar, S.; Tsai, T.-Y.; Young, T.-H.; Yang, H.J.; Ji, Y.-R. An electroactive alginate hydrogel nanocomposite reinforced by functionalized graphite nanofilaments for neural tissue engineering. Carbohydr. Polym. 2019, 224, 115112. [Google Scholar] [CrossRef] [PubMed]
- Kumar, S.; Karmacharya, M.; Joshi, S.R.; Gulenko, O.; Park, J.; Kim, G.-H.; Cho, Y.-K. Photoactive antiviral face mask with self-sterilization and reusability. Nano Lett. 2020, 21, 337–343. [Google Scholar] [CrossRef] [PubMed]
- Balagna, C.; Francese, R.; Perero, S.; Lembo, D.; Ferraris, M. Nanostructured composite coating endowed with antiviral activity against human respiratory viruses deposited on fibre-based air filters. Surf. Coat. Technol. 2021, 409, 126873. [Google Scholar] [CrossRef]
- Deshmukh, S.P.; Patil, S.; Mullani, S.; Delekar, S. Silver nanoparticles as an effective disinfectant: A review. Mater. Sci. Eng. C 2019, 97, 954–965. [Google Scholar] [CrossRef] [PubMed]
- Ciriminna, R.; Albo, Y.; Pagliaro, M. New Antivirals and Antibacterials Based on Silver Nanoparticles. ChemMedChem 2020, 15, 1619–1623. [Google Scholar] [CrossRef]
- Chen, N.; Zheng, Y.; Yin, J.; Li, X.; Zheng, C. Inhibitory effects of silver nanoparticles against adenovirus type 3 in vitro. J. Virol. Methods 2013, 193, 470–477. [Google Scholar] [CrossRef]
- Xiang, D.-X.; Chen, Q.; Pang, L.; Zheng, C.-l. Inhibitory effects of silver nanoparticles on H1N1 influenza A virus in vitro. J. Virol. Methods 2011, 178, 137–142. [Google Scholar] [CrossRef] [PubMed]
- Joe, Y.H.; Woo, K.; Hwang, J. Fabrication of an anti-viral air filter with SiO2–Ag nanoparticles and performance evaluation in a continuous airflow condition. J. Hazard. Mater. 2014, 280, 356–363. [Google Scholar] [CrossRef] [PubMed]
- De Faria, A.F.; Martinez, D.S.T.; Meira, S.M.M.; de Moraes, A.C.M.; Brandelli, A.; Souza Filho, A.G.; Alves, O.L. Anti-adhesion and antibacterial activity of silver nanoparticles supported on graphene oxide sheets. Colloids Surf. B Biointerfaces 2014, 113, 115–124. [Google Scholar] [CrossRef] [PubMed]
- Gurunathan, S.; Han, J.W.; Dayem, A.A.; Eppakayala, V.; Kim, J.-H. Oxidative stress-mediated antibacterial activity of graphene oxide and reduced graphene oxide in Pseudomonas aeruginosa. Int. J. Nanomed. 2012, 7, 5901. [Google Scholar] [CrossRef] [Green Version]
- Liu, S.; Hu, M.; Zeng, T.H.; Wu, R.; Jiang, R.; Wei, J.; Wang, L.; Kong, J.; Chen, Y. Lateral dimension-dependent antibacterial activity of graphene oxide sheets. Langmuir 2012, 28, 12364–12372. [Google Scholar] [CrossRef]
- Sametband, M.; Kalt, I.; Gedanken, A.; Sarid, R. Herpes simplex virus type-1 attachment inhibition by functionalized graphene oxide. ACS Appl. Mater. Interfaces 2014, 6, 1228–1235. [Google Scholar] [CrossRef]
- Ye, S.; Shao, K.; Li, Z.; Guo, N.; Zuo, Y.; Li, Q.; Lu, Z.; Chen, L.; He, Q.; Han, H. Antiviral activity of graphene oxide: How sharp edged structure and charge matter. ACS Appl. Mater. Interfaces 2015, 7, 21571–21579. [Google Scholar] [CrossRef]
- Chen, Y.-N.; Hsueh, Y.-H.; Hsieh, C.-T.; Tzou, D.-Y.; Chang, P.-L. Antiviral activity of graphene–silver nanocomposites against non-enveloped and enveloped viruses. Int. J. Environ. Res. Public Health 2016, 13, 430. [Google Scholar] [CrossRef] [PubMed] [Green Version]
- Srivastava, A.K.; Dwivedi, N.; Dhand, C.; Khan, R.; Sathish, N.; Gupta, M.K.; Kumar, R.; Kumar, S. Potential of graphene-based materials to combat COVID-19: Properties, perspectives, and prospects. Mater. Today Chem. 2020, 18, 100385. [Google Scholar] [CrossRef] [PubMed]
Publisher’s Note: MDPI stays neutral with regard to jurisdictional claims in published maps and institutional affiliations. |
© 2021 by the authors. Licensee MDPI, Basel, Switzerland. This article is an open access article distributed under the terms and conditions of the Creative Commons Attribution (CC BY) license (https://creativecommons.org/licenses/by/4.0/).